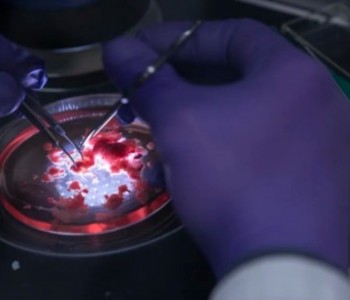

Блог History
всего записей -
2064
Блог History
всего записей -
2064
всего записей -
2064
BenQ выпустила игровой монитор с частотой 540 Гц для ПК и консолей
Помимо сверхвысокой частоты обновления, он предлагает специальную технологию для повышения чёткости картинки, подставку с удобной регулировкой и поддержку современных игровых консолей
Дизайн кампуса Tencent вдохновлён ДНК
Главная особенность здания в том, что оно состоит из четырёх соединённых между собой и «закрученных в вихре» башен
Для самолётов создали систему подавления турбулентности
Она делает полёты на самолётах плавнее и комфортнее, а ещё снижает расход топлива
Yamaha представила водородный лодочный мотор
Разработку покажут на Международной выставке лодок в Майами в 2024 году
Компьютер на базе клеток мозга смогли научить идентифицировать голоса
Состоит система из выращенной в лаборатории ткани человеческого мозга, обычных электронных схем и алгоритмов искусственного интеллекта
В Tesla Cybertruck предусмотрен режим для плавания
Автомобиль может преодолевать брод и даже плавать на расстояние в несколько сотен метров при условии отсутствия сильного волнения воды
Создана ткань объединяет в себе электропроводность и гибкость
Учёные из Университета штата Вашингтон придумали умное текстильное волокно, совмещающее в себе гибкость хлопка и электропроводность полианилина
Hyundai хочет запустить в производство умные шины со встроенной защитой от скольжения
В этой технологии используются модули из сплава с памятью формы
Изобретён способ печатать импланты прямо внутри тела
Это позволит проводить хирургические операции менее инвазивно, обеспечив возможность вводить имплантаты в жидком виде с последующим затвердеванием в необходимом месте
ИИ уже умеют считывать пароли по звуку нажимаемых клавиш
Британские исследователи разработали нейросеть, способную распознавать нажатия клавиш на компьютерной клавиатуре по звуку с уровнем точности до 95%
Открыт предварительный заказ на карточную игру по «Русам против ящеров»
Инди-игра «Русы против ящеров» всю осень потрясает интернет и грозится прийти в реальность. Ждать фанатам осталась совсем недолго
Создана автономная мини-клиника без персонала
Представлены самообслуживающие врачебные кабинеты с искусственным интеллектом
Renault представила бюджетный компактный электрокар 5 E-Tech
Компактный хэтчбек, сделанный по мотивам Renault 5 семидесятых годов, оказался очень похож на концепткар 2021 года
Китай уже создаёт контейнеровоз на передовом ториевом реакторе
В судне будет использоваться новый ториевый реактор на расплаве солей — как более безопасная альтернатива аналогам на уране
Фил Спенсер играл почти 150 часов в Starfield и взял 100-й уровень в Diablo IV
Спенсер опубликовал свою статистику за 2023 год в соцсети X
Утилита AntiFake сможет защитить голос от подделки
Учёные из Вашингтонского университета в Сент-Луисе придумали алгоритм AntiFake, который препятствует созданию голосовых дипфейков
Немецкий стартап может превращать ДВС-машины в электрокары
Под возможности электрификации попадают уже несколько десятков моделей
Теперь алмаз имеет достойного конкурента по прочности
Исследователи из Эдинбургского университета открыли практически неразрушимое вещество, способное посоревноваться с алмазом за звание самого твёрдого материала на Земле
Депутат Госдумы Ткачев назвал нарушением прав граждан новые правила Sony
В Госдуме оценили новые правила Sony, касающиеся перепродажи дисков
НТЦ ИТ «Роса»: Р-ФОН сам включает безопасный режим при приходе человека на работу
Стало известно, как реализована особая безопасность российского смартфона Р-ФОН